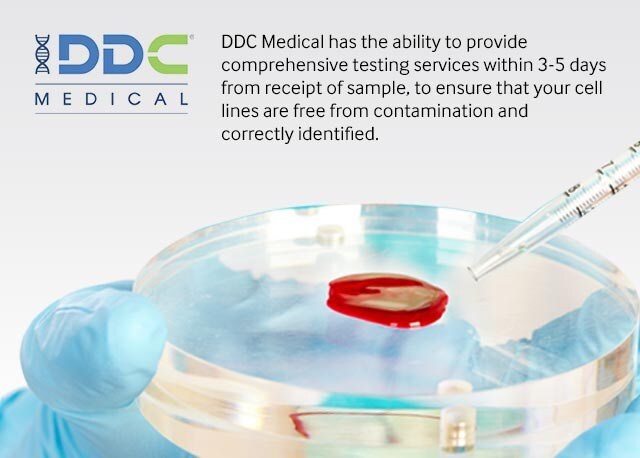

Hopefully, I can give someone else peace of mind. I rarely write reviews, but for this situation, I had to. I had no reason to worry before I read these negative reviews it's just so unnecessary! Thank you to all those who took the time to write all these positive reviews.

I too, was a worried mom-to-be because of the negative REVIEWS. I received my results today and am very happy.

She informed me when they received the blood sample and counted 7 days from there-which is today. I was initially upset because of the wait but she pointed out that the results come 7 days AFTER they get the blood sample (which IS advertised accordingly on their website). Nevertheless, she gave me the facts and details I needed- she did her job. Please be mindful that many of us are pregnant and already hormonal and freaking out, so it doesn't hurt to be a little nice. She was too "strong" for lack of a better word-kind of like she was on the defense already from all the other people calling to complain to her. Whatever the case, good customer service would have been nicer and more reassuring. I mean, in her defense, I did come off a little strongly because I was freaking out about the reviews and thought they were scamming me because it's already been over 2 weeks, so maybe she was just a bit defensive. And when I finally spoke to someone, I'm honestly going to say I was not feeling her vibe at all. Now, the reason why I gave 4 stars instead of 5 is because I had to wait 20 minutes to speak to a representative. C'mon, how many times have we seen this on Maury? Countless. You might want so badly for your child to be his that you find ways the baby looks like him (even though they are not related). If not, stop making the rest of us worry! The way your baby "looks" to YOU is SUBJECTIVE. All these women who have alleged false results, please follow up with some evidence. Women can be messed up too! Now, there's not much you can do about women being in denial. Another instance of fraud is when the mother uses the saliva of her other child-that IS indeed the child of the possible father-for her other kid. So, make sure he's not being sneaky, by doing it with him, or have a witness. Because it is very possible for your "baby daddy" to be a complete dirt bag and to get someone else, i.e. Now, to decrease chances of FRAUD, you need to do it the legal way-or just make sure you are all together conducting this test. I'd do a blood test for mom, and a swab for dad to decrease chance of human error. Also, in one case that I read, the swab of the mother was mistakenly switched with the child, so the father tested negative because they were testing the father and mother, instead of the father and child. Let me advise you of a way to reduce human error: If you have 2 or more possible fathers, don't get them swabbed at the same time, because chances for human error will increase in this instance (they switch swabs). However, human errors, although possible, are nevertheless rare. In other cases, (3) human error has occurred. Like really? I have come to the conclusion (after analyzing these reviews over and over), that a lot of these women are either in (1) denial or (2) fraud was committed without them realizing. And I will explain why I gave 4 stars: First of all, I want to say that all those bad reviews really almost gave me a darn stroke from all the stress it gave me. Reasons why results may not be what you expect.
